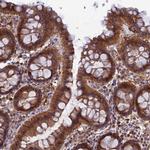
HINT1 Antibody in Immunohistochemistry (IHC)

Search
Invitrogen
HINT1 Polyclonal Antibody
{{$productOrderCtrl.translations['antibody.pdp.commerceCard.promotion.promotions']}}
{{$productOrderCtrl.translations['antibody.pdp.commerceCard.promotion.viewpromo']}}
{{$productOrderCtrl.translations['antibody.pdp.commerceCard.promotion.promocode']}}: {{promo.promoCode}} {{promo.promoTitle}} {{promo.promoDescription}}. {{$productOrderCtrl.translations['antibody.pdp.commerceCard.promotion.learnmore']}}

Please note: We are reviewing Western blot images included in the antibody testing data in our catalog, including those provided by third parties. Unless expressly labeled or annotated as “raw-unedited”, Western blot images included in the antibody testing data in our catalog may have been edited, optimized or otherwise adjusted for presentation.
产品信息
PA5-60760
种属反应
宿主/亚型
分类
类型
抗原
偶联物
形式
浓度
规格
纯化类型
保存液
内含物
保存条件
运输条件
RRID
产品详细信息
Immunogen sequence: IPKKHISQIS VAEDDDESLL GHLMIVGKKC AADLGLNKGY RMVVNEGSDG GQSVYHVHLH VL
Highest antigen sequence identity to the following orthologs: Mouse - 92%, Rat - 92%.
靶标信息
Histidine triad nucleotide-binding protein 1 (HINT1) is a member of the histidine triad (HIT) protein family, a group of small nucleotide-binding and -hydrolyzing proteins. HINT1 interacts with several diverse proteins and has been suggested to have tumor suppressive activities. HINT1 catalyzes the hydrolysis of adenosine 5'-monophoramidate substrates such as AMP-morpholidate, but its enzymatic function does not appear to play a role in its tumor suppression. Recent experiments demonstrate that HINT1 forms a complex with POSH and JNK in vivo, inhibiting AP-1 activity and the phosphorylation of c-Jun, and this action could contribute to the tumor suppressor activity of HINT1. Other studies raise the possibility of HINT1 as a candidate gene for schizophrenia.
仅用于科研。不用于诊断过程。未经明确授权不得转售。
篇参考文献 (0)
生物信息学
蛋白别名: 17 kDa inhibitor of protein kinase C; adenosine 5'-monophosphoramidase; Adenosine 5'-monophosphoramidase HINT1; Desumoylating isopeptidase HINT1; FLJ30414; FLJ32340; Histidine triad nucleotide-binding protein 1; PKC inhibitor/ interacting protein; PKCI-1; Protein kinase C inhibitor 1; protein kinase C, iota; Protein kinase C-interacting protein 1
基因别名: AA673479; HINT; HINT1; Ipk1; Pkci; PKCI-1; PKCI1; Prkci; PRKCNH1
UniProt ID: (Mouse) P70349, (Rat) P62959
Entrez Gene ID: (Mouse) 15254, (Rat) 690660




